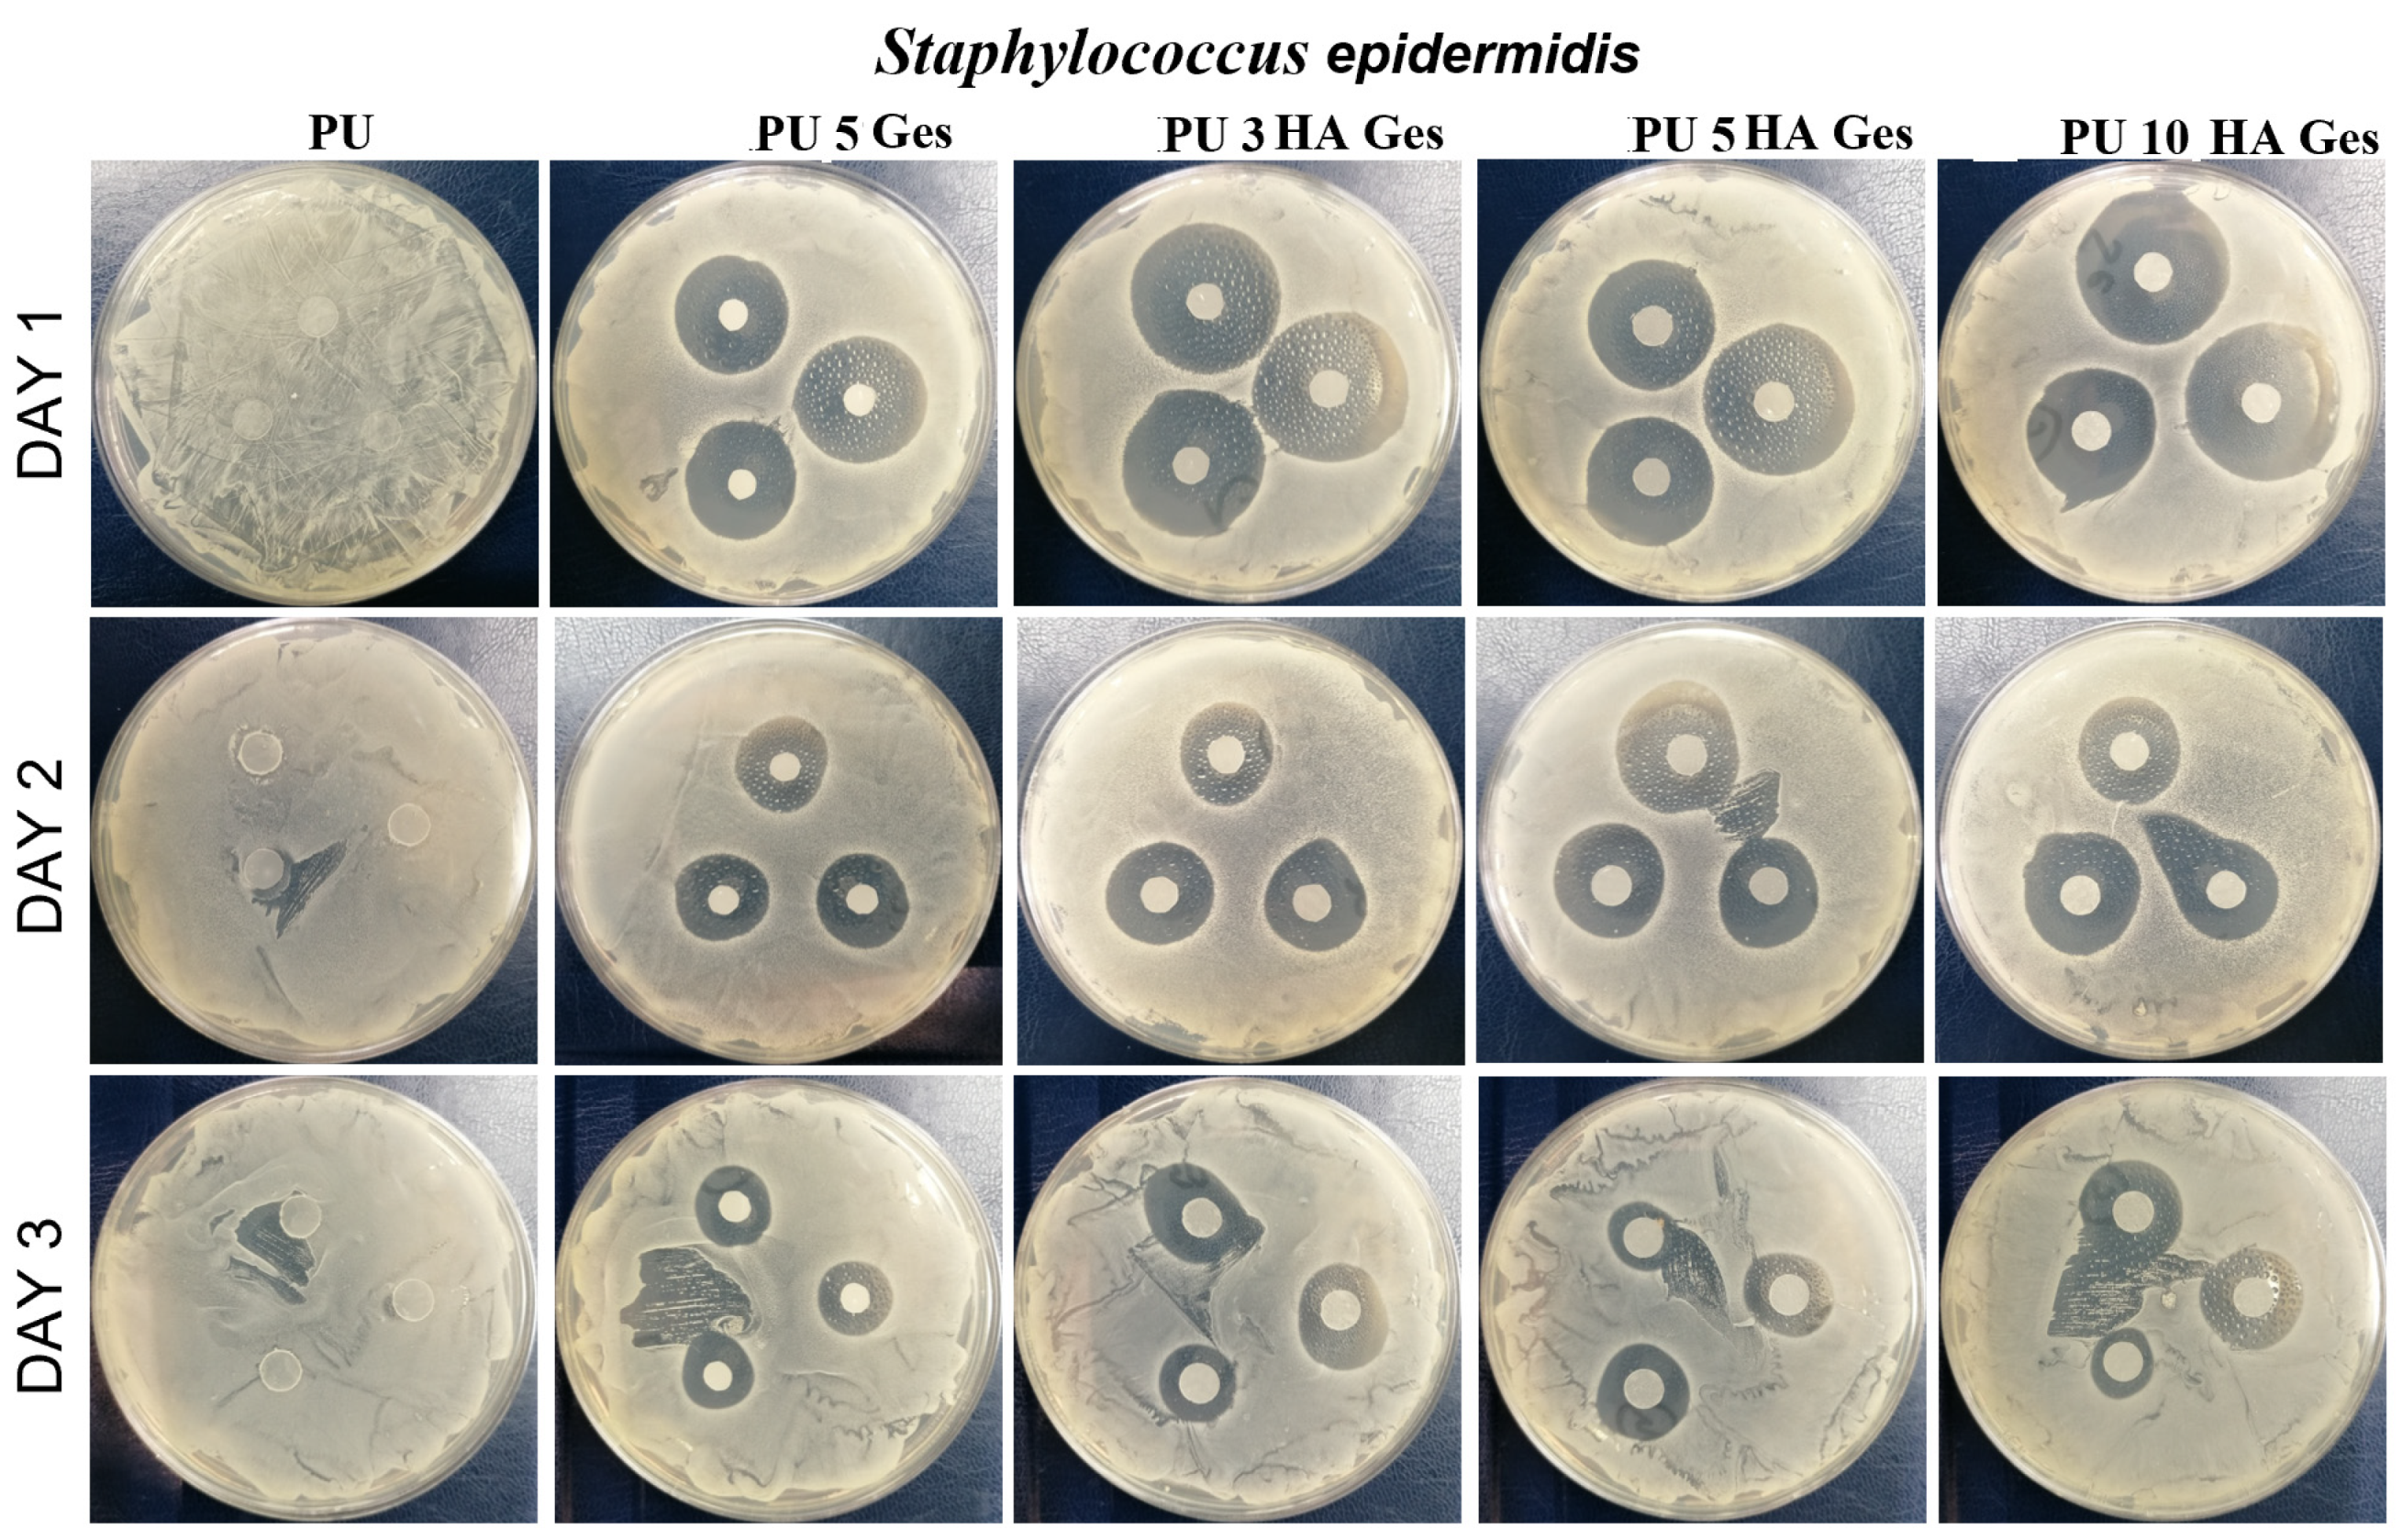
Polymers 15 00938 g009b Polymers 15 00938 g009b

Study of Correlation between Structure and Shape-Memory Effect/Drug-Release Profile of Polyurethane/Hydroxyapatite Composites for Antibacterial Implants
Abstract
1. Introduction
2. Materials and Methods
2.1. Materials
2.2. PU/HA/GeS-Composites Fabrication
2.3. Characterization
2.4. Shape Memory
2.5. In Vitro Drug-Release Study
2.6. Antibacterial Test
3. Results and Discussion
3.1. Characterization Results
3.2. Shape-Memory Results
3.3. Results of GeS-Release Study
3.4. Antibacterial Test Results
4. Conclusions
Author Contributions
Funding
Institutional Review Board Statement
Data Availability Statement
Conflicts of Interest
References
- Ong, K.L.; Yun, B.M.; White, J.B. New Biomaterials for Orthopedic Implants. Orthop. Res. Rev. 2015, 7, 107–130. [Google Scholar] [CrossRef]
- Henderson, J.H.; Davis, K.A.; Baker, R.M. Applications of Shape Memory Polymers (SMPs) in Mechanobiology and Bone Repair. In Biomaterials for Bone Regeneration: Novel Techniques and Applications, 1st ed.; Dubruel, P.P., Vlierberghe, S.V., Eds.; Woodhead Publishing: Cambridge, UK, 2014; pp. 111–146. [Google Scholar]
- Senatov, F.S.; Zadorozhnyy, M.Y.; Niaza, K.V.; Medvedev, V.V.; Kaloshkin, S.D.; Anisimova, N.Y.; Kiselevskiy, M.V.; Yang, K.C. Shape Memory Effect in 3D-Printed Scaffolds for Self-Fitting Implants. Eur. Polym. J. 2017, 93, 222–231. [Google Scholar] [CrossRef]
- Lendlein, A.; Behl, M.; Hiebl, B.; Wischke, C. Shape-Memory Polymers as a Technology Platform for Biomedical Applications. Expert Rev. Med. Devices 2010, 7, 357–379. [Google Scholar] [CrossRef]
- Delaey, J.; Dubruel, P.; van Vlierberghe, S. Shape-Memory Polymers for Biomedical Applications. Adv. Funct. Mater. 2020, 30, 1909047. [Google Scholar] [CrossRef]
- Zhang, D.; George, O.J.; Petersen, K.M.; Jimenez-Vergara, A.C.; Hahn, M.S.; Grunlan, M.A. A Bioactive “Self-Fitting” Shape Memory Polymer Scaffold with Potential to Treat Cranio-Maxillo Facial Bone Defects. Acta Biomater. 2014, 10, 4597–4605. [Google Scholar] [CrossRef]
- Yu, J.; Xia, H.; Ni, Q.Q. A Three-Dimensional Porous Hydroxyapatite Nanocomposite Scaffold with Shape Memory Effect for Bone Tissue Engineering. J. Mater. Sci. 2018, 53, 4734–4744. [Google Scholar] [CrossRef]
- Zhao, W.; Liu, L.; Zhang, F.; Leng, J.; Liu, Y. Shape Memory Polymers and Their Composites in Biomedical Applications. Mater. Sci. Eng. C 2019, 97, 864–883. [Google Scholar] [CrossRef] [PubMed]
- Caplin, J.D.; García, A.J. Implantable Antimicrobial Biomaterials for Local Drug Delivery in Bone Infection Models. Acta Biomater. 2019, 93, 2–11. [Google Scholar] [CrossRef]
- Li, L.; Yu, M.; Li, Y.; Li, Q.; Yang, H.; Zheng, M.; Han, Y.; Lu, D.; Lu, S.; Gui, L. Synergistic Anti-Inflammatory and Osteogenic n-HA/Resveratrol/Chitosan Composite Microspheres for Osteoporotic Bone Regeneration. Bioact. Mater. 2021, 6, 1255–1266. [Google Scholar] [CrossRef] [PubMed]
- Water, J.J.; Bohr, A.; Boetker, J.; Aho, J.; Sandler, N.; Nielsen, H.M.; Rantanen, J. Three-Dimensional Printing of Drug-Eluting Implants: Preparation of an Antimicrobial Polylactide Feedstock Material. J. Pharm. Sci. 2015, 104, 1099–1107. [Google Scholar] [CrossRef] [PubMed]
- Maroni, A.; Melocchi, A.; Zema, L.; Foppoli, A.; Gazzaniga, A. Retentive Drug Delivery Systems Based on Shape Memory Materials. J. Appl. Polym. Sci. 2020, 137, 48798. [Google Scholar] [CrossRef]
- Ciobanu, G.; Ignat, D.; Bull, C.L.-C. Polyurethane–Hydroxyapatite Bionanocomposites: Development and Characterization. Chem. Bull. 2009, 54, 57–60. [Google Scholar]
- Jackson, B.; Bow, A.; Kannarpady, G.; Biris, A.S.; David, E.; Anderson, D.E.; Dhar, M.; Shawn, E.; Bourdo, S.E. Polyurethane/Nano-Hydroxyapatite Composite Films as Osteogenic Platforms. Taylor Fr. 2018, 29, 1426–1443. [Google Scholar] [CrossRef] [PubMed]
- Turnbull, G.; Clarke, J.; Picard, F.; Riches, P.; Jia, L.; Han, F.; Li, B.; Shu, W. 3D Bioactive Composite Scaffolds for Bone Tissue Engineering. Bioact. Mater. 2018, 3, 278–314. [Google Scholar] [CrossRef] [PubMed]
- Ma, C.; Wei, Q.; Cao, B.; Cheng, X.; Tian, J.; Pu, H.; Yusufu, A.; Cao, L. A Multifunctional Bioactive Material That Stimulates Osteogenesis and Promotes the Vascularization Bone Marrow Stem Cells and Their Resistance to Bacterial Infection. PLoS ONE 2017, 12, e0172499. [Google Scholar] [CrossRef] [PubMed]
- Xia, Y.; He, Y.; Zhang, F.; Liu, Y.; Leng, J. A Review of Shape Memory Polymers and Composites: Mechanisms, Materials, and Applications. Adv. Mater. 2021, 33, 2000713. [Google Scholar] [CrossRef] [PubMed]
- Wischke, C.; Behl, M.; Lendlein, A. Expert Opinion on Drug Delivery Drug-Releasing Shape-Memory Polymers-the Role of Morphology, Processing Effects, and Matrix Degradation. Expert Opin. Drug Deliv. 2013, 10, 1193–1205. [Google Scholar] [CrossRef] [PubMed]
- Lendlein, A.; Trask, R.S. Multifunctional Materials: Concepts, Function-Structure Relationships, Knowledge-Based Design, Translational Materials Research. Multifunct. Mater. 2018, 1, 010201. [Google Scholar] [CrossRef]
- Ahmad, M.; Xu, B.; Purnawali, H.; Fu, Y.; Huang, W.; Miraftab, M.; Luo, J. High Performance Shape Memory Polyurethane Synthesized with High Molecular Weight Polyol as the Soft Segment. Appl. Sci. 2012, 2, 535–548. [Google Scholar] [CrossRef]
- Pandini, S.; Dioni, D.; Paderni, K.; Messori, M.; Toselli, M.; Bontempi, E.; Riccò, T. The Two-Way Shape Memory Behaviour of Crosslinked Poly(ϵ-Caprolactone) Systems with Largely Varied Network Density. J. Intell. Mater. Syst. Struct. 2016, 27, 1388–1403. [Google Scholar] [CrossRef]
- Xue, L.; Dai, S.; Li, Z. Synthesis and Characterization of Three-Arm Poly (Fi-Caprolactone)-Based Poly (Ester Urethanes) with Shape-Memory Effect at Body Temperature. Macromolecules 2009, 42, 964–972. [Google Scholar] [CrossRef]
- Zhuohong, Y.; Jinlian, H.; Yeqiu, L.; Lapyan, Y. The Study of Crosslinked Shape Memory Polyurethanes. Mater. Chem. Phys. 2006, 98, 368–372. [Google Scholar] [CrossRef]
- Meng, Q.; Hu, J.; Zhu, Y. Properties of Shape Memory Polyurethane Used as a Low-Temperature Thermoplastic Biomedical Orthotic Material: Influence of Hard Segment Content. J. Biomater. Sci. Polym. Ed. 2008, 19, 1437–1454. [Google Scholar] [CrossRef] [PubMed]
- Wang, L.; Yang, X.; Chen, H.; Gong, T.; Li, W.; Yang, G.; Zhou, S. Design of Triple-Shape Memory Polyurethane with Photo-Cross-Linking of Cinnamon Groups. ACS Appl. Mater. Interfaces 2013, 5, 10520–10528. [Google Scholar] [CrossRef] [PubMed]
- Liu, W.; Zhao, Y.; Wang, R.; Li, J.; Li, J.; Luo, F.; Tan, H.; Fu, Q. Post-Crosslinked Polyurethanes with Excellent Shape Memory Property. Macromol. Rapid Commun. 2017, 38, 1700450. [Google Scholar] [CrossRef]
- Hu, J.; Yang, Z.; Yeung, L.; Ji, F.; Liu, Y. Crosslinked Polyurethanes with Shape Memory Properties. Polym. Int. 2005, 54, 854–859. [Google Scholar] [CrossRef]
- Wischke, C.; Neffe, A.T.; Steuer, S.; Lendlein, A. Evaluation of a Degradable Shape-Memory Polymer Network as Matrix for Controlled Drug Release. J. Control. Release 2009, 138, 243–250. [Google Scholar] [CrossRef]
- Bil, M.; Kijeńska-Gawrońska, E.; Głodkowska-Mrówka, E.; Manda-Handzlik, A.; Mrówka, P. Design and in Vitro Evaluation of Electrospun Shape Memory Polyurethanes for Self-Fitting Tissue Engineering Grafts and Drug Delivery Systems. Mater. Sci. Eng. C 2020, 110, 110675. [Google Scholar] [CrossRef]
- Chen, L.; Wang, J.X.; Tang, C.Y.; Chen, D.Z.; Law, W.C. Shape Memory Effect of Thermal-Responsive Nano-Hydroxyapatite Reinforced Poly-d-l-Lactide Composites with Porous Structure. Compos. B Eng. 2016, 107, 67–74. [Google Scholar] [CrossRef]
- Nahavandizadeh, N.; Rezaei, M. Preparation of Shape Memory Polyurethane/Hydroxyapatite Nanocomposite Scaffolds by Electrospinning Method and Investigation of Their Microstructure and Physical-Mechanical Properties. Polym.-Plast. Technol. Mater. 2020, 59, 1562–1573. [Google Scholar] [CrossRef]
- Mi, H.Y.; Palumbo, S.M.; Jing, X.; Turng, L.S.; Li, W.J.; Peng, X.F. Thermoplastic Polyurethane/Hydroxyapatite Electrospun Scaffolds for Bone Tissue Engineering: Effects of Polymer Properties and Particle Size. J. Biomed. Mater. Res. B Appl. Biomater. 2014, 102, 1434–1444. [Google Scholar] [CrossRef] [PubMed]
- Yan, B.; Gu, S.; Zhang, Y. Polylactide-Based Thermoplastic Shape Memory Polymer Nanocomposites. Eur. Polym. J. 2013, 49, 366–378. [Google Scholar] [CrossRef]
- Yu, J.; Xia, H.; Teramoto, A.; Ni, Q.Q. The Effect of Hydroxyapatite Nanoparticles on Mechanical Behavior and Biological Performance of Porous Shape Memory Polyurethane Scaffolds. J. Biomed. Mater. Res. A 2018, 106, 244–254. [Google Scholar] [CrossRef] [PubMed]
- Du, K.; Gan, Z. Shape Memory Behaviour of ha-g-PDLLA Nanocomposites Prepared via in Situ Polymerization. J. Mater. Chem. B 2014, 2, 3340–3348. [Google Scholar] [CrossRef] [PubMed]
- Senatov, F.S.; Niaza, K.V.; Zadorozhnyy, M.Y.; Maksimkin, A.V.; Kaloshkin, S.D.; Estrin, Y.Z. Mechanical Properties and Shape Memory Effect of 3D-Printed PLA-Based Porous Scaffolds. J. Mech. Behav. Biomed. Mater. 2016, 57, 139–148. [Google Scholar] [CrossRef] [PubMed]
- Li, Y.; Li, Y.-H.; Wang, F.-A.; Ren, B. Viscometric and FTIR Studies of Chloroquine Phosphate, Acefylline Piperazine and Gentamicin Sulfate in Aqueous-Polyethylene Glycol and Aqueous-Polyvinyl Pyrrolidone at Different Temperatures. J. Chem. Thermodyn. 2013, 66, 14–21. [Google Scholar] [CrossRef]
- Zaleski, S.; Clark, K.A.; Smith, M.M.; Eilert, J.Y.; Doty, M.; van Duyne, R.P. Identification and Quantification of Intravenous Therapy Drugs Using Normal Raman Spectroscopy and Electrochemical Surface-Enhanced Raman Spectroscopy. Anal. Chem. 2017, 89, 2497–2504. [Google Scholar] [CrossRef] [PubMed]
- Meng, Q.; Hu, J. Influence of Heat Treatment on the Properties of Shape Memory Fibers. I. Crystallinity, Hydrogen Bonding, and Shape Memory Effect. J. Appl. Polym. Sci. 2008, 109, 2616–2623. [Google Scholar] [CrossRef]
- Nie, D.; Yin, X.; Cai, Z.; Wang, J. Effect of Crystallization on Shape Memory Effect of Poly (Lactic Acid). Polymers 2022, 14, 1569. [Google Scholar] [CrossRef] [PubMed]
- Purcar, V.; Rădiţoiu, V.; Nichita, C.; Bălan, A.; Rădiţoiu, A.; Căprărescu, S.; Raduly, F.M.; Manea, R.; Şomoghi, R.; Nicolae, C.A.; et al. Preparation and Characterization of Silica Nanoparticles and of Silica-Gentamicin Nanostructured Solution Obtained by Microwave-Assisted Synthesis. Materials 2021, 14, 2086. [Google Scholar] [CrossRef]
- Trovati, G.; Sanches, E.A.; Neto, S.C.; Mascarenhas, Y.P.; Chierice, G.O. Characterization of Polyurethane Resins by FTIR, TGA, and XRD. J. Appl. Polym. Sci. 2010, 115, 263–268. [Google Scholar] [CrossRef]
- Ciecierska, E.; Jurczyk-Kowalska, M.; Bazarnik, P.; Kowalski, M.; Krauze, S.; Lewandowska, M. The Influence of Carbon Fillers on the Thermal Properties of Polyurethane Foam. J. Therm. Anal. Calorim. 2016, 123, 283–291. [Google Scholar] [CrossRef]
- Szlachta, M.; Ordon, K.; Nowicka, K. Thermal properties of polyurethane-based composites modified with chitosan for biomedical applications. J. Therm. Anal. Calorim. 2021, 143, 3471–3478. [Google Scholar] [CrossRef]
- Hu, J.L.; Ji, F.L.; Wong, Y.W. Dependency of the Shape Memory Properties of a Polyurethane upon Thermomechanical Cyclic Conditions. Polym. Int. 2005, 54, 600–605. [Google Scholar] [CrossRef]
- Jeelani, S.; Mohammed, Z.; Staszczak, M.; Kalat, M.N.; Golasí Nski, K.M.; Urbá Nski, L.; Takeda, K.; Matsui, R.; Zbieta, E.; Pieczyska, A. Characterization of Polyurethane Shape Memory Polymer and Determination of Shape Fixity and Shape Recovery in Subsequent Thermomechanical Cycles. Polymers 2022, 14, 4775. [Google Scholar] [CrossRef]
- Macha, I.J.; Ben-Nissan, B.; Möller, W. Kinetics and the Theoretical Aspects of Drug Release from PLA/HAp Thin Films. Key Eng. Mater. 2017, 758, 113–119. [Google Scholar] [CrossRef]
- Padmaa Paarakh, M.; Ani Jose, P.; Setty, C.M.; Christoper, G.V.P. Release Kinetics-Concepts and Applications. IJPRT 2018, 8, 12–20. [Google Scholar] [CrossRef]
- Ribeiro, M.; Monteiro, F.J.; Ferraz, M.P. Infection of orthopedic implants with emphasis on bacterial adhesion process and techniques used in studying bacterial-material interactions. Biomatter 2012, 2, 176–194. [Google Scholar] [CrossRef]

| Sample | Tg, °C | Tm1 °C | ΔH1, J/g | χc, % | Tm2 | ΔH2, J/g | Water Contact Angle ° |
|---|---|---|---|---|---|---|---|
| PU | −48 | 41 | 22 | 24 | 115 | 10 | 93 ± 3.4 |
| PU 5 GeS | −48 | 41 | 21 | 23 | 108 | 9 | 88 ± 3.2 |
| PU 3 HA GeS | −48 | 42 | 20 | 22 | 101 | 9 | 74 ± 2.7 |
| PU 5 HA GeS | −49 | 42 | 19 | 21 | 99 | 8 | 65 ± 3.8 |
| PU 10 HA GeS | −50 | 41 | 21 | 23 | 97 | 8 | 61 ± 2.6 |
| Sample | Peak I Max, °C | Peak II, °C | Peak III Max, °C | Peak IV, °C | T, Weight Loss 5% | Residual Weight, % |
|---|---|---|---|---|---|---|
| PU/GeS | 227 | 289 | 370 | 404/535 | 266 | 0.3 |
| PU 3HA/GeS | 232 | 294 | 386 | 406/528 | 278 | 3.5 |
| PU 5HA/GeS | 232 | 295 | 385 | 520 | 274 | 5.7 |
| PU 10 HA/GeS | 233 | 297 | 387 | 522 | 285 | 8.5 |
| Sample | Zero Order | 1st Order | Higuchi | Korsmeyer–Peppas | |
|---|---|---|---|---|---|
| Regression Co-Efficient R2 Value | Diffusion Exponent (n) | ||||
| PU 5 GeS | 0.856 ± 0.028 | 0.933 ± 0.008 | 0.976 ± 0.005 | 0.972 ± 0.014 | 0.37 ± 0.03 |
| PU 3 HA GeS | 0.616 ± 0.05 | 0.805 ± 0.04 | 0.861 ± 0.02 | 0.939 ± 0.04 | 0.38 ± 0.08 |
| PU 5 HA GeS | 0.680 ± 0.02 | 0.862 ± 0.008 | 0.871 ± 0.01 | 0.971 ± 0.012 | 0.32 ± 0.08 |
| PU 10 HA GeS | 0.694 ± 0.073 | 0.808 ± 0.09 | 0.871 ± 0.06 | 0.952 ± 0.027 | 0.42 ± 0.06 |
Disclaimer/Publisher’s Note: The statements, opinions and data contained in all publications are solely those of the individual author(s) and contributor(s) and not of MDPI and/or the editor(s). MDPI and/or the editor(s) disclaim responsibility for any injury to people or property resulting from any ideas, methods, instructions or products referred to in the content. |
© 2023 by the authors. Licensee MDPI, Basel, Switzerland. This article is an open access article distributed under the terms and conditions of the Creative Commons Attribution (CC BY) license (https://creativecommons.org/licenses/by/4.0/).
Share and Cite
Bil, M.; Jurczyk-Kowalska, M.; Kopeć, K.; Heljak, M. Study of Correlation between Structure and Shape-Memory Effect/Drug-Release Profile of Polyurethane/Hydroxyapatite Composites for Antibacterial Implants. Polymers 2023, 15, 938. https://doi.org/10.3390/polym15040938
Bil M, Jurczyk-Kowalska M, Kopeć K, Heljak M. Study of Correlation between Structure and Shape-Memory Effect/Drug-Release Profile of Polyurethane/Hydroxyapatite Composites for Antibacterial Implants. Polymers. 2023; 15(4):938. https://doi.org/10.3390/polym15040938
Chicago/Turabian StyleBil, Monika, Magdalena Jurczyk-Kowalska, Kamil Kopeć, and Marcin Heljak. 2023. "Study of Correlation between Structure and Shape-Memory Effect/Drug-Release Profile of Polyurethane/Hydroxyapatite Composites for Antibacterial Implants" Polymers 15, no. 4: 938. https://doi.org/10.3390/polym15040938
APA StyleBil, M., Jurczyk-Kowalska, M., Kopeć, K., & Heljak, M. (2023). Study of Correlation between Structure and Shape-Memory Effect/Drug-Release Profile of Polyurethane/Hydroxyapatite Composites for Antibacterial Implants. Polymers, 15(4), 938. https://doi.org/10.3390/polym15040938

